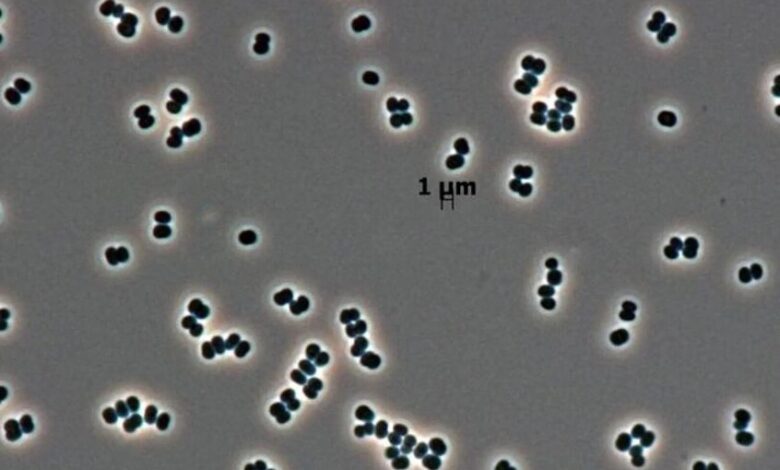

بكتيريا “تتظاهر بالموت” داخل أشد المنشآت الأرضية تعقيما!
روافدنيوز/ متابعة
اكتشف العلماء قدرة استثنائية لنوع نادر من البكتيريا عثر عليها داخل أشد المنشآت الأرضية تعقيما، حيث تستطيع الدخول في سبات عميق يخفي كل علامات الحياة، في ما وصف بـ”الموت المزيف”.
ويدق الاكتشاف، الذي نشر تفصيلا في دورية Microbiology Spectrum، ناقوس الخطر حول بروتوكولات حماية الكواكب، مثيرا تساؤلات حول إمكانية انتقال ميكروبات أرضية إلى عوالم أخرى دون اكتشافها.
وفي عام 2007، رصد علماء ناسا للمرة الأولى بكتيريا “مكورة فينيكس النظيفة” (Tersicoccus phoenicis) في غرفتي تجميع معزولتين للمركبات الفضائية، تفصل بينهما مسافة 4000 كيلومتر. وظل وجود هذا الكائن في هاتين الغرفتين، اللتين تخضعان لأقسى عمليات التعقيم الممكنة، لغزا يحير العلماء لسنوات.
وخلال الدراسة الجديدة، أخضع العلماء البكتيريا لظروف قاسية متعمدة، وحرموها من جميع المغذيات وعرضوها للجفاف الشديد. والنتيجة كانت مفاجئة: خلال 48 ساعة فقط، دخلت البكتيريا في حالة خمود تام، متوقفة عن جميع النشاطات الأيضية بشكل يجعلها غير قابلة للكشف بوسائل الفحص التقليدية التي تعتمد على البحث عن علامات الحياة.
ويوضح الدكتور مدهان تيرومالاي، عالم الأحياء الدقيقة بجامعة هيوستن والمؤلف الرئيسي للدراسة، في تصريح سابق لـ”ناشيونال جيوغرافيك”: “إنها ليست ميتة، بل كانت تتظاهر بالموت، إنها في حالة سبات عميق فحسب”.
وتبنى المركبات الفضائية في منشآت فائقة النظافة تخضع لعمليات تعقيم متعددة المراحل تشمل التعرض للحرارة الشديدة والمواد الكيميائية القاتلة للميكروبات والأشعة فوق البنفسجية والإشعاع، بهدف واضح: منع أي تلوث بيولوجي عابر للكواكب. والهدف مزدوج، حماية رواد الفضاء، وضمان أن أي علامات لحياة تكتشف على كواكب أخرى تكون أصلية وليست “متطفلة” من الأرض.
وتطرح قدرة هذه البكتيريا على النجاة من هذه العمليات القاسية، ثم التخفي بنجاح عن كواشف الفحص النهائي، تحديا كبيرا لفعالية البروتوكولات الحالية. والأمر يكتسب أهمية خاصة عند معرفة أن إحدى الغرفتين التي اكتشفت فيها البكتيريا كانت تستخدم في تحضيرات مهمة “مركبة فينيكس” التي هبطت على المريخ عام 2008.
ويثير هذا الاكتشاف سؤالا مقلقا يتعلق بإمكانية أن تكون هذه البكتيريا، أو غيرها من الميكروبات ذات القدرات المشابهة، قد رافقت المركبات الفضائية إلى المريخ أو عوالم أخرى دون أن يتم اكتشافها.
ويستبعد الخبراء بقاءها على السطح المكشوف للمريخ نظرا لقسوة الظروف، لكنهم يبدون قلقا أكبر إزاء إمكانية استيطانها في “ملاجئ” محمية تحت السطح أو في شقوق الصخور، حيث تزداد فرص بقائها حية في حالة السبات هذه.
ومن ناحية أخرى، يطرح العلماء نظرية بديلة وهي أن هذه البكتيريا قد تكون تطورت خصيصا للتكيف مع بيئة غرف المركبات النظيفة، وهو ما قد يفسر سبب عدم العثور عليها في أي بيئة طبيعية أخرى على الأرض حتى الآن.
ورغم ما يثيره الاكتشاف من مخاوف، إلا أن فهم الآلية الدقيقة التي تسمح لهذه البكتيريا بـ”إطفاء” عملية الأيض لديها وإعادة تنشيط نفسها قد يمكن العلماء من تطوير طرق فحص أكثر حساسية، قادرة على كشف الكائنات الخالة. كما يفتح الباب أمام تصميم بروتوكولات تعقيم جديدة تستهدف هذه الحالة الخاصة من السبات، ما يعزز من فاعلية عمليات التنظيف في المنشآت الحساسة ويرفع سقف ضمانات “النظافة البيولوجية” للمركبات الفضائية في المستقبل./انتهى




